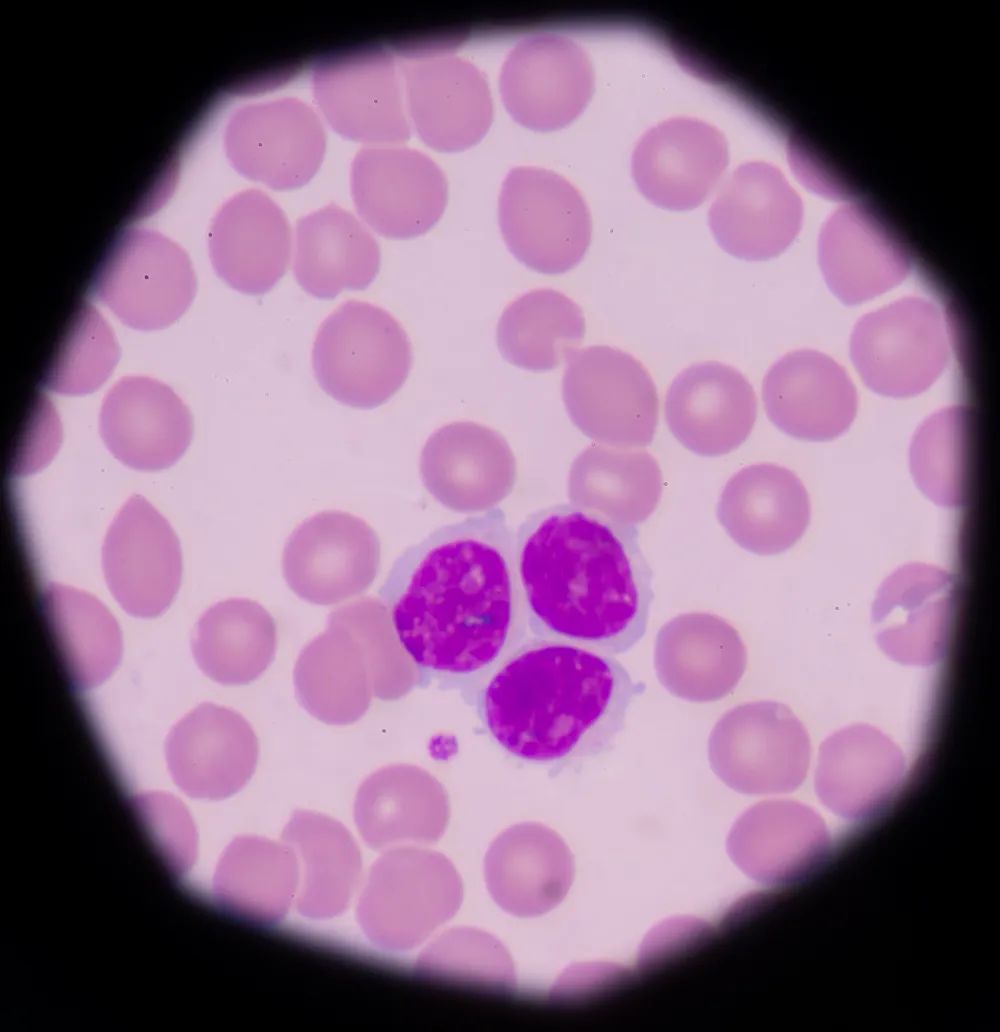
1.jpg

身体健康的“必需品”——免疫细胞
我们的身体健康离不开免疫细胞,如同我们的日常生活离不开衣食住行。人类能够安然存活于世几十载,有的人甚至到耄耋之年依旧身体健硕、思维活跃,这与自身体内的强大免疫系统息息相关。
免疫细胞,人类通过肉眼直接观察,并不能识别出来的微小个体。然而,却蕴含着巨大的能量,关系到人类的生老病死。
(显微镜下的免疫细胞)
每个成年人体内大概有2万亿个免疫细胞,这支队伍随着人体的成长,也在不断变化。这些免疫细胞可以大致划分为两个派别,先天性免疫系统成员与适应性免疫系统成员,他们携手共存,相互协作,一致对外。
先天性免疫系统成员
人体出生自带的免疫细胞,是由于人类为了生命健康不断进化而存留在人体内免疫细胞种类。如自然杀伤细胞(NK细胞)、肥大细胞、嗜酸性粒细胞、嗜碱性粒细胞、包括巨噬细胞和中性粒细胞在内的吞噬细胞、以及树突细胞。这些细胞的作用在于识别和消灭可能导致感染的病原体。
NK细胞是先天免疫中的“种子选手”,是人体抵抗癌细胞和病毒感染的第一道防线,可非特异性直接杀伤肿瘤细胞,这种天然杀伤活性既不需要抗原致敏,也不需要抗体参与,且无MHC限制。除了具有强大的杀伤功能外,还具有很强的免疫调节功能,与机体其他多种免疫细胞相互作用,调节机体的免疫状态和免疫功能。
适应性免疫系统成员
在后天环境的训练,一群初出茅庐的“呆萌小士兵”在历经各种病菌的袭击后,逐渐成长为高级战士,捍卫着细胞王国的和平,守护人体的身体健康。如B细胞和T细胞。
人体的免疫力在25岁左右达到顶峰,在40岁仅剩最高峰时的1/2,而70岁时仅有1/10。免疫细胞是身体免疫力的关键成员,随着年龄增长,人体内的“免疫细胞群”质量逐步下降,数量越来越少,识别以及击杀病毒、细菌、异常细胞的能力减弱。这也是老年人更容易生病、患癌的原因。
我们可以选择提前存储免疫细胞种子细胞,来备份免疫力。保存越早,备份的免疫细胞多样性越丰富,免疫潜能越高,越有可能有效治疗疾病、降低患病风险和抗衰老。因此,在身体健康时越早储存,质量越好。
本文为科普性知识,仅供学习、交流,请勿用于商业用途。
参考资料:
1、关于NK细胞,你需要知道什么? 干细胞者说
2、免疫力是第一生命力,李先亮
—————————————————————————————————————————————————
汉氏联合可提供胎盘脐带源干细胞、免疫细胞存储服务,在全国布局了7个临床级细胞库,通过了ISO9001:2015国际质量体系认证,2个实验室拥有CNAS认证,并且有7款自主研发的干细胞I类新药通过中国和法国药监局临床试验默示许可。以韩忠朝院士为首的科研团队发表论文500余篇,在国际SCI杂志发表300余篇。主编参编英文专著9部,中文专著10部。同时,公司承担政府支持的重大项目研究,拥有几十项细胞相关专利技术。全国设立多个研发平台,涵盖工程实验室、研究中心、院士专家工作站、博士后工作站、高校联合实验室等,致力于细胞技术造福人类健康,提升人类生命质量。

